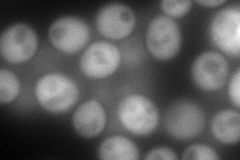
YBR020W
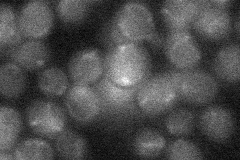
YBR020W
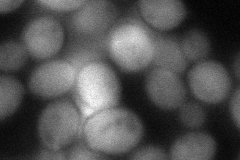
YBR020W
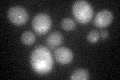
YBR020W
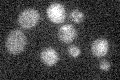
YBR020W

View description
Galactokinase, phosphorylates alpha-D-galactose to alpha-D-galactose-1-phosphate in the first step of galactose catabolism; expression regulated by Gal4p
Localization:
Intensity:
Fold change:
Significance:
-
C’ GFP library in SD

below threshold15.36 -
N' NOP1pr-GFP in SD
cytosol192.694 -
N' TEF2pr-mCherry in SD

missing0 -
N' NATIVEpr-GFP in SD
below threshold19.1168 -
N' TEF2pr-VC and Cyto-VN in SD
cytosol76.8374 -
C’ GFP library in SD+DTT
cytosol15.961.03No -
C’ GFP library in SD+H2O2

cytosol15.240.99No -
C’ GFP library in Starvation Media
cytosol15.671.02No -
C’ GFP library on the background of Pup2-DaMP

below threshold -
C’ GFP library on the background of CCT mutant

below threshold18.32161.19224No
